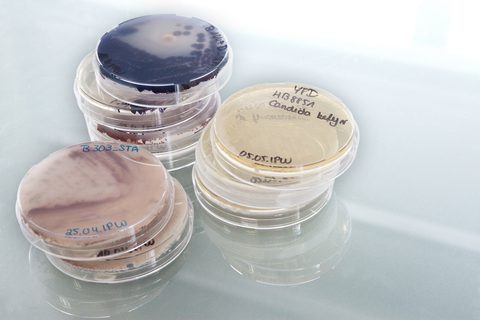
BRAIN Kultursammlung Mikroorganismen

Enzymes are a key technology of modern pharmaceuticals and life sciences, playing a crucial role in drug development, bioprocessing, and diagnostics. As the demand for specialised and high-performance enzymes continues to grow, companies face a fundamental challenge: how to efficiently scale up enzyme production from laboratory development to commercial manufacturing.
Enzyme production via fermentation remains a complex process . The success of scaling up depends not only on the enzyme itself but on the production strain that produces it. Choosing the right microbial host, optimising production efficiency, and ensuring scalability are all critical to making enzyme manufacturing commercially viable.
At the core of every enzyme production process lies a carefully selected microbial host strain - bacteria, fungi, or yeast - designed to produce the target enzyme with high efficiency, stability, and yield. The choice of strain has a direct impact on commercial scalability, influencing factors such as:




Developing a high-performance industrial production strain is one of the most technically challenging aspects of enzyme manufacturing. It requires precise integration of strain engineering, process optimisation, and scalability to ensure the enzyme performs consistently and efficiently at industrial scale.
This long and costly development cycle delays innovation and limits market access, particularly for biotech start-ups and mid-sized pharmaceutical companies that may not have the infrastructure to support large-scale fermentation.
Addressing these challenges requires a holistic approach that integrates advanced strain engineering, optimised fermentation processes, and scalable production platforms. By leveraging innovative strain optimisation techniques like CRISPR/Cas and robust fermentation platforms, companies can significantly reduce time to market, improve cost efficiency, and ensure regulatory compliance. The key to success lies in developing high-performance microbial strains that deliver consistent, high-yield enzyme production at an industrial scale. As demand for pharmaceutical and life science enzymes continues to grow, embracing cutting-edge bioprocessing solutions will be essential for companies looking to stay competitive, mitigate supply chain risks, and accelerate the development of next-generation enzyme-based products.
At BRAINBiocatalysts Life Science Solutions, we combine powerful Plug & Produce platforms using bacteria, yeast and fungi with expert strain development services to help scale with confidence. Whether you're licensing a production-ready system or developing a bespoke solution, we deliver high-performance strains designed for industrial success.